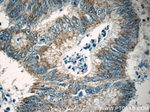
FAU Antibody in Immunohistochemistry (Paraffin) (IHC (P))

Search
Proteintech
FAU Polyclonal Antibody
{{$productOrderCtrl.translations['antibody.pdp.commerceCard.promotion.promotions']}}
{{$productOrderCtrl.translations['antibody.pdp.commerceCard.promotion.viewpromo']}}
{{$productOrderCtrl.translations['antibody.pdp.commerceCard.promotion.promocode']}}: {{promo.promoCode}} {{promo.promoTitle}} {{promo.promoDescription}}. {{$productOrderCtrl.translations['antibody.pdp.commerceCard.promotion.learnmore']}}
产品信息
13581-1-AP
种属反应
宿主/亚型
分类
类型
抗原
偶联物
形式
浓度
规格
纯化类型
保存液
内含物
保存条件
运输条件
产品详细信息
Immunogen sequence: MQLFVRAQE LHTFEVTGQE TVAQIKAHVA SLEGIAPEDQ VVLLAGAPLE DEATLGQCGV EALTTLEVAG RMLGGKVHGS LARAGKVRGQ TPKVAKQEKK KKKTGRAKRR MQYNRRFVNV VPTFGKKKGP NANS (1-133 aa encoded by BC033877)
靶标信息
This gene is the cellular homolog of the fox sequence in the Finkel-Biskis-Reilly murine sarcoma virus (FBR-MuSV). It encodes a fusion protein consisting of the ubiquitin-like protein fubi at the N terminus and ribosomal protein S30 at the C terminus. It has been proposed that the fusion protein is post-translationally processed to generate free fubi and free ribosomal protein S30. Fubi is a member of the ubiquitin family, and ribosomal protein S30 belongs to the S30E family of ribosomal proteins. Whereas the function of fubi is currently unknown, ribosomal protein S30 is a component of the 40S subunit of the cytoplasmic ribosome and displays antimicrobial activity. Pseudogenes derived from this gene are present in the genome. Similar to ribosomal protein S30, ribosomal proteins S27a and L40 are synthesized as fusion proteins with ubiquitin.
仅用于科研。不用于诊断过程。未经明确授权不得转售。
生物信息学
蛋白别名: 40S ribosomal protein S30; FAU; FAU ubiquitin like and ribosomal protein S30 fusion; FAU ubiquitin-like and ribosomal protein S30; FAU-encoded ubiquitin-like protein; FBR-MuSV-associated ubiquitously expressed; Finkel-Biskis-Reilly murine sarcoma virus (FBR-MuSV) ubiquitously expressed (fox derived); Finkel-Biskis-Reilly murine sarcoma virus (FBR-MuSV) ubiquitously expressed (fox derived) protein; Finkel-Biskis-Reilly murine sarcoma virusubiquitously expressed; MNSF-beta; monoclonal non-specific suppressor factor beta; monoclonal nonspecific suppressor factor beta; monoclonal nonspecific suppressor factor betamonoclonal nonspecific suppressor factor beta; ribosomal protein S30; RP MNSFbeta; small ribosomal subunit protein eS30; Ubiquitin-like FUBI-ribosomal protein eS30 fusion protein; ubiquitin-like protein FUBI; ubiquitin-like protein fubi and ribosomal protein S30; ubiquitin-like-S30 fusion protein; unnamed protein product
基因别名: asr1; eS30; FAU; FAU1; Fub1; Fubi; MNSFbeta; RPS30; S30
UniProt ID: (Human) P62861, (Mouse) P62862
Entrez Gene ID: (Human) 2197, (Mouse) 14109, (Rat) 29752